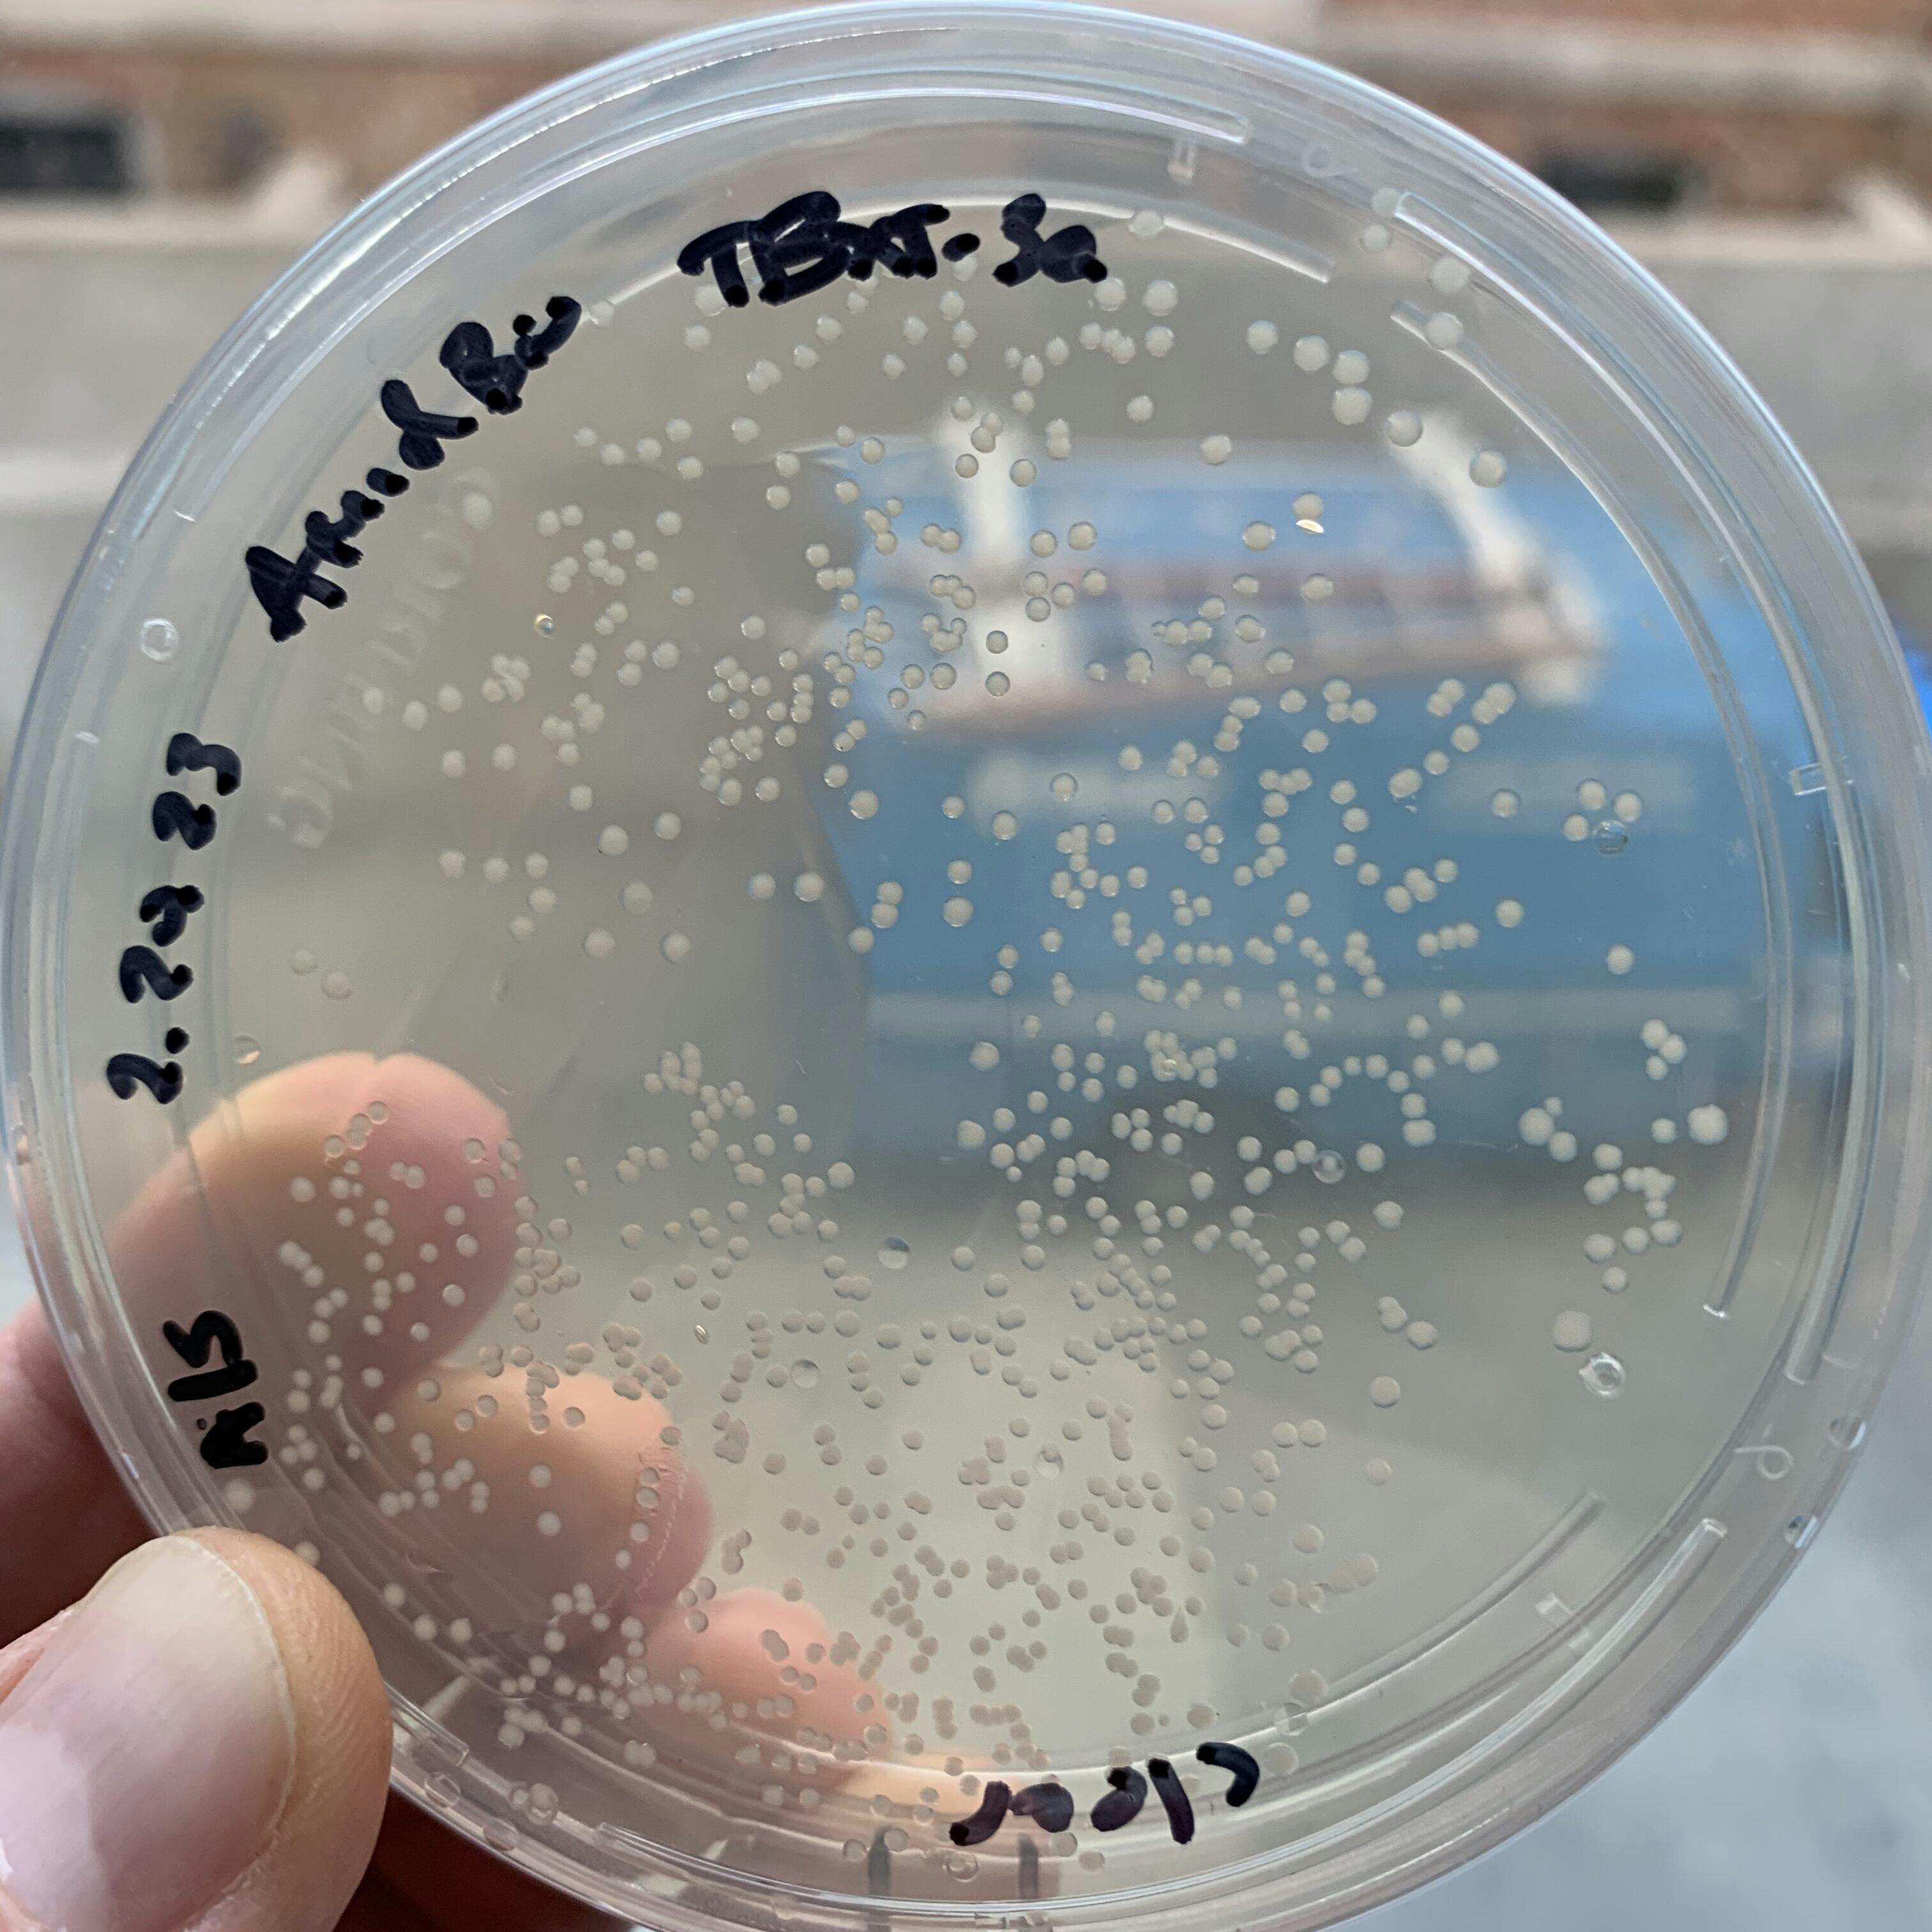

Photo: Lee Dolat, PhD and Dan Freed, PhD at Chordoma Foundation Labs
Dr. Lee Dolat, our newest bench scientist, is certainly not new to working in a research laboratory. For over a decade he has been developing new research approaches and generating new knowledge about how our cells and bodies work in labs at Massachusetts General Hospital, Drexel University, and Duke Medical Center. But after just one day with Chordoma Foundation Labs he says “it [was] unlike anything I’ve been a part of before–a whole new world.” Why? Because the day-to-day, minute-to-minute focus in this lab is singular: accelerating progress for chordoma patients.
Lee first heard of chordoma when he met Josh Sommer, our Co-Founder and Executive Director, in the local community. After hearing the Foundation’s story, he says he couldn’t get chordoma out of his head. He found himself periodically searching the web to learn about chordoma: How are people studying this incredibly rare disease? Has anything new been discovered about the underlying biology? Is there anything new in therapeutics? When he saw the opening at Chordoma Foundation Labs, he jumped at the chance to join the team finding new answers to these questions.
Now on the inside, Lee is seeing the difference a patient-driven research lab can make for overcoming the tough challenges in chordoma research: Running experiments with patient-derived cells, and looking specifically at which samples respond to certain treatments and why, provides an uncommon opportunity to make discoveries that matter. With the strong foundation that the lab’s director, Dan Freed, PhD, and fellow bench scientist Nindo Punturi have built in the lab, Lee says he “was able to hit the ground running” and start working with the sense of urgency that patients deserve. Lee also notes how impressed he has been with Dan’s scientific leadership. Whether it's deciding which scientific questions need to be answered next to launch a new clinical trial or striking partnerships with pharmaceutical companies and doctors to ensure their findings are guiding new treatments, Lee says Dan’s translational research savvy ensures that everything being done in the lab prioritizes the end goal: improving patient treatments and searching for cures.
And the team is just as excited about the difference Lee will make to their progress. “Lee has rounded out our scientific team nicely, and his arrival opens new doors for us experimentally,” says Dan. “With a strong track record of success across multiple different scientific disciplines, Lee has accumulated a rare blend of skills that run the gamut from biochemistry to cell biology to immunology,” he adds. This breadth of experience perfectly positions Lee and, by extension, the team to tackle many of the key unanswered questions at the cutting edge of chordoma research and therapeutic development.
In his first strides out of the gate, Lee is bringing his skills to advance our Brachyury Drug Discovery Initiative, our effort to catalyze the development of new therapies targeting brachyury, which is necessary for chordoma tumor growth. Our Chordoma Foundation Labs team is accelerating the pace of this initiative by bringing together resources from across the research community to test brachyury-targeted drug candidates in-house. Right away, Lee jumped into this effort, testing brachyury-targeted molecules developed at an early-stage biotech company for their effect on patient-derived chordoma cell lines from our repository. At the same time, Lee is bringing his breadth of experience to set up new approaches for testing promising compounds in the lab, for example to confirm compounds act directly on the brachyury protein and to enable measurements of how strongly compounds can stop brachyury-driven processes in the cell. Gathering these types of information about promising molecules using chordoma cells from patients gives our initiative the greatest chance to successfully deliver effective targeted therapies to improve patient outcomes.
Lee holds colonies of bacteria that are engineered to produce brachyury in Chordoma Foundation Labs
Up next, Lee will bring key aspects of our Immunotherapy Initiative in-house, as well. Cancer immunotherapy, a type of treatment that harnesses a patient’s immune system to fight tumors, has radically improved the lives of many cancer patients, but there are fundamental research questions left to answer about how the immune system recognizes chordoma before this approach can be best deployed against this disease. How is the chordoma evading our body’s natural immune response in the first place? Where are the different types of immune cells in relation to the tumor and what functional state are they in? Are there differences between patients in how the immune system is behaving? Chordoma Foundation investments have started to answer some of these questions, but harnessing these insights to test new therapeutic strategies is critical and urgent for chordoma patients. This is where Lee’s previous work building complex disease models (like organoids) and studying the interaction between immune cells and organ tissues will come in handy. Lee’s next task is to build the capabilities at Chordoma Foundation Labs to enable evaluation of existing and novel immunotherapies in models of chordoma.
While he stays busy in the lab, Lee is eager to make new connections with researchers, physicians and drug developers at this year’s International Chordoma Research Workshop, which he knows can help spur the team's progress all the more. But he says it’s the Chordoma Foundation and the chordoma community that keeps him focussed and inspired to tackle the task before him each day. Lee speaks not just of the incredible early achievements of Chordoma Foundation Labs, like moving an insight from the lab into the clinic in less than a year, but also the inspiring work of his colleagues on the Patient Services team. “We’re doing patient-centered research,” Lee says with confidence, “and I’m just as impressed by what’s going on beyond the research at the Chordoma Foundation – it’s really incredible.”
With an urgency inspired by patients, Lee is determined to see his work with the team make an impact on things that we can do. He knows that for many patients, surgery and radiation are still the only option for treatment. Whether breakthrough comes through targeting brachyury, harnessing the immune system, or other therapies, Lee says he hopes “we can recommend a true targeted therapy and understand what each specific patient needs.” And the team has high hopes for what they can accomplish this year with Lee on board. “He's relentless in his approach,” Dan says, “and I'm incredibly excited for the year ahead.”
Story by Shelby Doyle, PhD
Sign up for our newsletter
To learn about exciting recent research results, newly launched projects, and how you can help drive progress, subscribe to our newsletter.